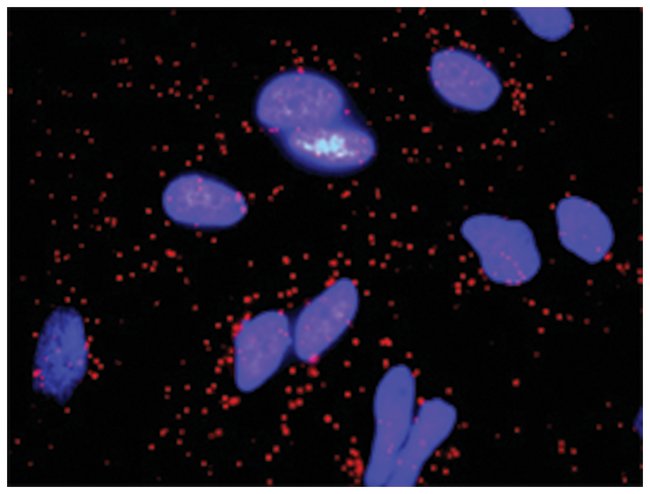

Anti-Fgfr2, Fgf10 Protein Protein Interaction Antibody Pair, Abnova, Each
$ 2,025.00
|
|
Details:
This protein protein interaction antibody pair set comes with two antibodies to detect the protein-protein interaction, one against the FGFR2 protein, and the other against the FGF10 protein for use in in situ Proximity Ligation Assay.Host Species: Rabbit, MouseSpecies Reactivity: HuIn situ PLA
Additional Information
| SKU | 10268885 |
|---|---|
| UOM | Each |
| UNSPSC | 12352203 |
| Manufacturer Part Number | DI0199 |
